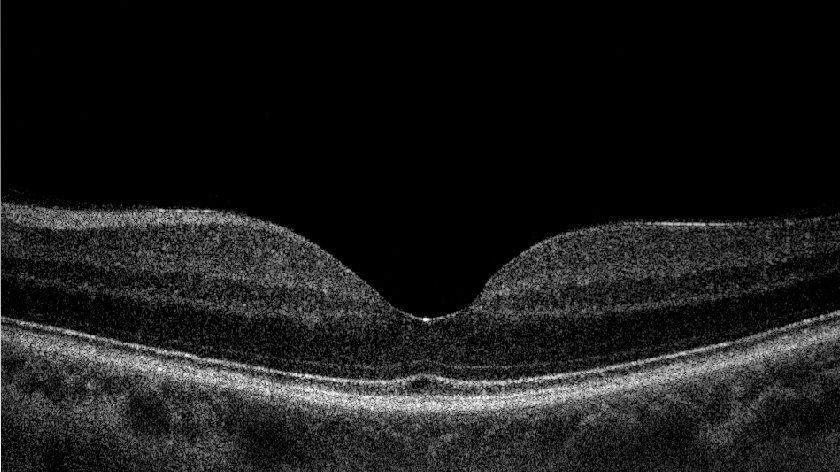

Trattamenti e terapie a Bologna per la degenerazione maculare senile
La degenerazione maculare legata all'età (DMLE) o senile (AMD) è una patologia multifattoriale che colpisce la zona centrale della retina, detta macula. È ad andamento progressivo e può portare alla perdita completa ed irreversibile della visione centrale.
Nei paesi industrializzati è la prima causa di ipovisione nei soggetti di età superiore ai 50 anni. Colpisce di solito a partire dai 60 anni e la sua frequenza aumenta nella popolazione all'aumentare dell'età. È quasi sempre bilaterale.
Le cause della malattia sembrano essere genetiche e legate all'ambiente. Il fumo è considerato un fattore di rischio grave, dose dipendente.
DMLE umida o neovascolare
La DMLE umida o neovascolare comprende circa il 10% della casistica patologica.
Le caratteristiche peculiari:
- presenza significativa di edema (liquido) maculare;
- Drusen molli. I depositi hanno diffusione spaziale maggiore, con bordi indistinti. La proliferazione di vasi sanguigni, dovuta all'ipossia, tende ad aggravare il quadro clinico;
- presenza frequente di emorragie sotto retiniche.
OCT
La tecnica trova largo uso in oftalmologia e ha numerose altre applicazioni biomediche. L'OCT sfrutta un raggio laser infrarosso analogamente a quello che fa un sonar con i fondali (a livello acustico), e riesce a ricostruire al computer la struttura Retinica, del Nervo Ottico e della Cornea, in due o tre dimensioni.
Consente, ad esempio, lo studio in sezione della Retina (Fig. 1a.b) e la diagnosi di eventuali patologie come DMS umida, Foro Maculare, Pucker Maculare, Edema diabetico e Edema infiammatorio, lo studio del nervo ottico e delle fibre nervose e quindi permette di fare una diagnosi precoce di glaucoma e di seguire poi l’evoluzione della patologia nel tempo.
Infine, consente di analizzare gli strati della cornea ed è quindi utile al fine di diagnosticare malattie degenerative corneali (cheratocono) ed è utilizzabile anche nel seguire il decorso post operatorio di alcuni interventi (trapianto di cornea, trapianto di cornea lamellare, Intacs, Lasik).
Contatta l’oculista se sospetti di soffrire di degenerazione maculare senile. Per prenotare una visita medica